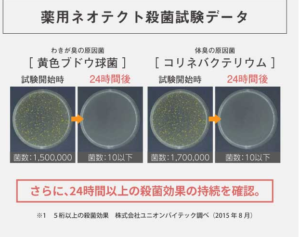

😳 周りの異性にニオイがバレていないか心配…
そんな貴方の悩みをすっきり解消してくれるのが…
肌のキメを整えながら、
汗のニオイ・ワキガの悩みを
しっかりケアしてくれる制汗クリームです❣️
✨ 毎日のケアで、自信の持てる快適なワキまわりへ。
大切な人との距離も、もっと近づけます💕

今だけ30%OFFの5580円(税込)でお試しできます!
回数制限がないので1回だけのお試しも可能なので安心ですよ😀
ただしとても人気のために売り切れてしまう可能性がありますのでお早めにお試しください❣
| 商品名 | 薬用ネオテクト |
| 内容量 | 30g |
| 分類 | 医薬部外品 |
| 期待できるメリット | ワキガ、足の臭い、汗臭い 、デリケートゾーンの臭い、 すそわきが(スソガ)、チチガ、加齢臭、脇汗、足汗、手汗のケア。 |
| おすすめ度 | ★★★★★5個 |
| 効果を感じられる目安 | 1ヶ月から2か月(個人差あり) |
| 定期初回の値段 | 5580円(税込) (6820円もお得) |
| 2回目以降の値段 | 5580円(税込) (12250円もお得) |
| 特典 | 30日毎に 送料無料でお届け |
| 原産国 | 日本 |
| 性別は? | ユニセックス |
| 口コミ | ★★★★★5,0 |
| おすすめの人 | ワキの汗のにおいで悩んでいる人 脚のにおいをなんとかしたい人おすすめ |
| 公式サイト | https://brandnewstore.jp/ |
目次
- 1 薬用ネオテクトの最安値情報!知らないと大損!
- 2 薬用ネオテクトのお支払方法は?
- 3 薬用ネオテクトの楽天,amazon,yahooショッピングの値段は?
- 4 薬用ネオテクトのドラッグストア、ロフト、イオン、ドンキの値段を比較
- 5 薬用ネオテクトのメルカリの値段は?
- 6 薬用ネオテクトの汗のニオイで困らない防臭効果、制汗ケアの秘密は
- 7 薬用ネオテクトのマイクロテクノロジーで長時間密着
- 8 薬用ネオテクトで健やかな肌状態へ導く効果の秘密
- 9 薬用ネオテクトの副作用は?敏感肌でも使える?
- 10 薬用ネオテクトが効果なし?誤解の原因はこれ!
- 11 薬用ネオテクトの効果的な使い方!これが正解です
- 12 薬用ネオテクトを実際に使っている女性の口コミ、評判!体験談を暴露
- 13 薬用ネオテクトはPococeでも話題
- 14 薬用ネオテクトの体験談!私の本音
- 15 薬用ネオテクトは雑誌でも話題
- 16 薬用ネオテクトの口コミのまとめ
- 17 薬用ネオテクトのメリットとデメリットは
- 18 薬用ネオテクトのメリットとデメリットは
- 19 薬用ネオテクトのまとめ
- 20 薬用ネオテクトの販売会社
薬用ネオテクトの最安値情報!知らないと大損!
薬用ネオテクトを購入する上で覚えておきたい
最安値の取扱店舗情報を紹介します
薬用ネオテクトの公式通販の値段
| 通常価格 | 7980円(税込) |
| 公式通販定期初回割引価格 | 30%OFFの5580円(税込)✨ |
| 1日あたりの値段 | 186円 |
薬用ネオテクトの2回目以降の値段
薬用ネオテクトの

毎月30日サイクルで
定期的にお届け
薬用ネオテクトの解約等の変更の手続きは

お電話不要マイページから行えますよ

特典
サイン不要の
ポスト投函で
手に入れる
事が出来る
薬用ネオテクトは
送料無料
また
初めての
方でも
安心の
30日間
全額返金
保証付き

できない場合
でもお金が
戻ってきますので
安心ですよ
薬用ネオテクトのお支払方法は?
クレジットカード払い
代金引換、後払いなどに対応してます
薬用ネオテクトの楽天,amazon,yahooショッピングの値段は?
薬用ネオテクトの楽天
amazon,yahooショッピングの値段を比較してみました
薬用ネオテクトの楽天の値段

5580円(税込)
薬用ネオテクトのamazonの値段

5580円(税込)
薬用ネオテクトのyahooショッピングの値段

5,909円
薬用ネオテクトの最安値は公式通販
楽天、amazonで同じ5580円(税込)
ですがamazonと比較しても2500円もお得!全額返金保証付き
また、安心して継続して手に入る等の特典があるのは公式通販だけ
追記
@コスメストア
7389円
セブンネットショッピング
販売なし
qoo10で5,580円
au pay マーケットで5,580円
最安値の公式通販でお試しください
薬用ネオテクトのドラッグストア、ロフト、イオン、ドンキの値段を比較
薬用ネオテクトのドラッグストアロフト、イオン、ドンキの
値段を比較してみました
薬用ネオテクトのドラッグストア(マツモトキヨシの値段)
マツモトキヨシでは市販されていません

薬用ネオテクトのロフトの値段
ロフトでは市販されていません

薬用ネオテクトのイオンの値段
イオンでは市販されていません

薬用ネオテクトのドンキの値段
ドンキでは市販されていません

| 店舗名 | お取り扱い状況 |
| PLAZA | 市販されてません |
| 東急ハンズ | 市販されてません |
| コストコ | 市販されてません |
| カインズ | 市販されてません |
| ココカラファイン | 市販されてません |
| サンドラッグ | 市販されてません |
| ウエルシア | 市販されてません |
| Vドラッグ | 市販されてません |
| キリン堂 | 市販されてません |
| コスモス | 市販されてません |
| イトーヨーカドー | 市販されてません |
| 龍生堂薬局 | 市販されてません |
| トモズ | 市販されてません |
| そうごう薬局 | 市販されてません |
| クオール薬局 | 市販されてません |
| アイン薬局 | 市販されてません |
| ロジャース | 市販されてません |
| ジェーソン | 市販されてません |
| 洋服のたかはし | 市販されてません |
| 島忠 | 市販されてません市販されてません |
| コーナン |
薬用ネオテクトは通販限定のために実店舗では取り扱いがありませんですので、薬用ネオテクトの公式通販のキャンペーンをチェックしてみましょう
薬用ネオテクトのメルカリの値段は?

薬用ネオテクトは
メルカリでも出品のされてます
ただし、個人が出品しているものなので
偽物転売品の可能性もありますそれなら
薬用ネオテクトの公式通販で安全な本物を格安
価格でお試しください
薬用ネオテクトの汗のニオイで困らない防臭効果、制汗ケアの秘密は

女性を悩ませる
汗による
ニオイのトラブル対策に
実績のある話題の
アイテムです
スメルハラスメントなど
汗のにおいに
よるトラブルケアに
最適です
薬用ネオテクトは
効果、効能が
認められて、
多くの女性の
長年のニオイの
悩みを
解決できる
秘密は
その有効成分に
よるものです
フェノールスルホン酸亜鉛

引き締めて
汗を
抑える効果を
発揮汗の出口を蓋
をする働きが
期待できます
シメン-5-オール

が期待できます
ニオイの原因は
ワキなどの皮膚に
雑菌が増えてしまう
事が原因なので
事実
薬用ネオテクトを
使用後

ワキガ臭の原因の
黄色ブドウ球菌は
試験開始時
菌数が
1500000が
24時間後には
菌数
10以下に
体臭の原因菌の
コリネバクテリウム
試験開始時
菌数
1700000が
24時間後には
10以下に激減
さらに
24時間以上
殺菌効果を持続を
確認してます
株式会社
ユニオン
ハイテック調べ
2015年8月
薬用ネオテクトのマイクロテクノロジーで長時間密着

薬用ネオテクトは
マイクロクリームという
ナノ化したクリームを
採用
肌に密着して
ニオイの原因を抑える
肌環境を
キープ
さらにウォーター
ブルーフ採用で
長時間の
持続効果を実現
薬用ネオテクトで制汗と殺菌を実現
さらさらな肌へ
汗や雑菌が
ニオイの原因
汗を
放置して
雑菌が
繁殖して
肌荒れの原因に
汗を
拭く回数が
多くなると
肌へのダメージも
多くなります
制汗&殺菌
ナノ化した
マイクロ
クリームで
長時間の制汗&殺菌
効果を持続
さらさらした質感を
実現
薬用ネオテクトで健やかな肌状態へ導く効果の秘密
薬用ネオテクトは
制汗効果毛ではなく
整った
肌へと導く
美肌効果も期待
できます
その秘密は以下の
有効成分のおかげ
アシタバエキス

肌荒れ改善効果
肌の柔軟性を
高めます
メマツヨイグサ抽出液

の色素沈着抑制へ健やかな肌へ導く
オウゴンエキス

コバネバナの
根から
抽出したエキス殺菌、
収れん効果と
高い保湿力
アップ効果
が期待できる
ドクダミエキス

肌の新陳代謝を
促して
美白効果
チャエキス

活性酸素を
抑える働き
老化対策や
肌荒れの予防にも
有効
茶乾留液

豊富、お肌を
健やか
整える
紅茶エキス

<ツバキ科の 植物 から抽出される 効果 ニキビケアに効果 が期待出来る/div>
ウーロン茶エキス

減らす
ポリフェノールが
豊富!
SOD酵素を
活性化させます
柿タンニン

塗ると
毛穴を
引き締める
働きが期待
プラセンタエキス

修復する働き
ニキビケアに有効
ヒアルロン酸

キープする肌にハリと弾力を
与える
アロエエキス

健やかに導く
埋没した
ニキビ跡ケアに有効
ヨクイニンエキス

から働きかけて肌の水分代謝を
促します
シャクヤクエキス

肌の炎症を防ぐ
チロシナーゼの
働きを抑える
トレハロース

る
紫外線に
よる肌のダメージを
抑え
ワレモコウエキス

肌のゆるみを抑制
肌の炎症を抑制
カオリン

肌を明るくさせる
働き
メントール

へ
肌の
引き締めを実現して
キメの整った肌
以上の
有効成分が
配合されているので
薬用ネオテクトを
使うことで
お肌のキメを調え
美肌へと導いてくれるのです
靴をぬいだ
時のにおいが
きつい
全身の部位ごとの
制汗剤を使うのが
面倒で辛い
制汗剤を
他の
人に使っているのが
バレると恥ずかしい
こちらの
悩みを抱える
方におすすめ
洗っても落ちない悩みは間違ったにおいケアが原因

こんなにおいケアは要注意
![]()
制汗スプレーを押さえつける

粉で押さえつけても
一時的に
汗は止めてもにおいは止まらない
一日に何度も吹きかける
負担が大きい
香水でニオイをごまかす

体臭と香水が混ざることで
ニオイが強くなることも
いい香りが逆効果になり本人も
不本意な結果に
石鹸を泡立てて洗うだけ

石鹸で体を
洗っても1日中キープ
できないので
時間と共に
少しづつにおいが復活
します。
洗うだけでは消えない悩み
実はにおいは

菌の繁殖を防ぐ
だけではなく
においの発生を
抑えることで変わります。

そこで
皮膚汗臭
制汗
ワキガ
への効果、効能が
医薬部外品として
認められた
薬用ネオテクトが誕生

実感を追求した清涼感
続く、においケア
\今なら初回限定2,980円でお試し!/
薬用ネオテクトの副作用は?敏感肌でも使える?
>
薬用ネオテクトを
これから
使う時に
弊害になるのが
安全性だとおもいます❣
薬用ネオテクトが
敏感肌でも使えるのか
調べてみました
薬用ネオテクトは
副作用のリスクが低い✨
デオドラントケア
薬用ネオテクトが、
副作用のリスク
が低い理由は
以下の条件を
見事に
達成してるから
7つの無添加達成!

デリケートな肌でも
使えるように
薬用ネオテクトは
酸化防止
不使用
紫外線吸収剤
不使用
石油系界面活性剤
不使用
着色料
不使用
合成香料
不使用
鉱物油
不使用
パラベン
不使用
を徹底してます。
子供の優しい肌
でも使えます✨
アレルギーテスト済み

ただし、
全てのアレルギー
の人に
使えるわけでは
ありません
薬用ネオテクトはメイドインジャパン

薬用ネオテクトは
プロ使用の
高品質の
商品を作るために
全て国内で
製造します
専門のスタッフが一つ一つ
厳しい検査をして
高い品質管理のもと
作られてます
敏感肌でも
使用できる
薬用ネオテクトで
さらさらの
匂いで困らない
肌を手に入れてみませんか
薬用ネオテクトが効果なし?誤解の原因はこれ!

薬用ネオテクトをこれから
使う時にさまざまなところで
評判を調べている方も
多いはず
そこで
薬用ネオテクト
を使ってみたけど
効果なし
だったと誤解を
する方も
いるかもしれません
でも安心して欲しいのが
それが
誤解による物だから
薬用ネオテクトを効果なしと誤解する人の傾向

即効性を期待する
使い方が適当
という点
薬用ネオテクト
は高い品質のデオドラント
ケアですが
即効性
はありません
薬用ネオテクトは
最低でも3週間以上
理想は2ヶ月使うことが大事
また、
薬用ネオテクトは
清潔な肌につかうことで
汗や体臭
予防効果が期待できます
薬用ネオテクトは楽天でも評価

薬用ネオテクトは
楽天の
デオドラントクリーム
部門で
制汗クリーム部門と
併せて
2019、1月9日売り上げ
No.1を達成
しているので、安心して
お試しくださいね
薬用ネオテクトの効果的な使い方!これが正解です
![]()
薬用ネオテクト
をこれから
使う上で
覚えておきたい
効果的な使い方を
解説します
薬用ネオテクトの使い方の流れ

清潔な
肌に
薬用ネオテクトを適量
1-2㎝ほど
チューブから出します

気になるところに
塗ってください
薬用ネオテクトはどこに使える?


薬用ネオテクト
は、ワキ、
足、首元、
胸、背中
うなじなどに
使えます
マッサージするように
馴染ませてください
薬用ネオテクトのテクスチャーは?

弾力が
あり伸びの良い
テクスチャー
べとつきも
ありません
薬用ネオテクトのテクスチャーの効果はどれくらい持続?

個人差があります
1日、朝晩の
ケアで
持続する
ように開発
夏場など
汗を描く時期や
外出で
気になったラ
清潔にしてから
塗ってください
薬用ネオテクトを実際に使っている女性の口コミ、評判!体験談を暴露

薬用ネオテクト
をこれから
使う人に
見てもらいたい
実際に
薬用ネオテクト
を使う女性の
口コミ、評判を紹介
薬用オテクトの公式サイトの良い口コミ
子どもが近くに通ると嫌がるくらい嫌な匂いがするみたい
ワキガでずっと悩んでいたので何とかしたいと本気で考えていたところ
見つけたのが薬用ネオテクト薬用ネオテクトをつけてから脇が全然においわないので安心してます
制服などの汗ジミでも困らなくなったので
ホッとしているのが正直な感想です
汗染みでお悩みの方におすすめ♪
子どもが近くにいるとウっと思うくらい
ワキガ
本人も気にしてました
ドラッグストアのものだと
あまり効果がなくてネオテクトを
使ってもらいました
制服のシャツの脇も臭いわないし
地肌も無臭になれてます
ワキガ施術経験者です
前よりも脇の臭いは減っても完全には..
どうしても気温が上がってくると
匂いを防げずに悩んでいましたドラッグストアで市販されているものは
個人的には効果が薄かったり、するので
悩んでいた時に見つけたのが薬用ネオテクトテクスチャも意外と軽めで、
使ってみたら臭いも減っていたのでこれはと思って
継続してます
匂いの元の菌を殺菌してくれるみたいなので
気に入ってますワキガで悩みたくない人はこれがおすすめ♪
[char no=”3″ char=”ちさ”]足が1日の仕事を終えた後でも臭いが気にならなくなった
乳液のようなテクスチャーでべとつきません
臭いので
周りの人に
迷惑かけてないのか
心配でした
薬用ネオテクト
をその時に知って
薬用ネオテクト
を実際に
使ってみたところ
朝、
足に
薬用ネオテクトを
塗ると
1日中、ニオイを
しっかり押さえながら
足の蒸れも
予防できるので
助かってます[/char]
引用 公式サイト
これからの季節に大活躍する
薬用ネオテクトコンパクトなので
カバンに入れて持ち運びが簡単仕事中にワキ汗をかきやすいので強い味方です
薬用ネオテクトのようなニオイゼロタイプの
デオドラントクリームは夏に重宝
特に営業などの仕事をしている人は
他の人に迷惑にならない
[char no=”4″ char=”えりこ”]チューブタイプで薬用ネオテクトを使うことで
加齢臭も収まってきたような
夜、夫と一緒に寝てる時も
避けられることが減った
ニオイが
気になるところに
ぬるだけ
ジェル状の
テクスチャーで
伸びもとっても
いいんですよ
お肌もサラサラに
運動の後に
シャワーを
浴びて
薬用ネオテクト
を塗るだけで
汗臭さも気にならないので
便利[/char]
引用 公式サイト
加齢臭が
収まって
夫自信が
喜んでる[/char]
引用 公式サイト
[char no=”5″ char=”なつみ”]スポーツの後に
使うと
汗臭い
ニオイから
解放されます[/char]
引用 公式サイト
[char no=”4″ char=”えりこ”]結構、汗っかきで
夕方になると
ワキ汗が
匂う
事が多くて
困ってました
同時に加齢臭も
薬用ネオテクト
はちょっと硬めの
テクスチャ
肌に
馴染ませると
グングンなじみます
薬用ネオテクトを
使うと
制汗効果が
高いので
夕方以降の
汗の量も
気になりません
また
異性がそばに
いても不安に
なることが
少なくなりました[/char]
引用 公式サイト
薬用ネオテクトの公式サイトの悪い口コミ
[char no=”6″ char=”なつみ”]薬用ネオテクトは汗で
べとべとの
時に使って
もあまり効果が
ないみたいです[/char]
引用 公式サイト
薬用ネオテクトのamazonの口コミ
[char no=”5″ char=”なつみ”]敏感肌で夏になると痒みが出て悩んでいました
肌に優しそうな
これを使ってみたところ
トラブルなく
ワキのにおいも
気になりません[/char] 引用 amazon[char no=”4″ char=”えりこ”] ワキガ対策のクリームですが
私は足のにおいケアに
使ってます
冬場の
ブーツのにおいが
ムレて
嫌なにおいをするのが
減りました
クリームタイプなので
塗りやすいのが良いですね[/char]
引用 amazon
[char no=”3″ char=”ちさ”]
長時間
消臭効果が
高いので
塗りなおす手間もありません[/char]
引用 amazon
[char no=”3″ char=”ちさ”]制汗剤や
香水で
ごまかしてきたけど
薬用ネオテクト
はニオイに
しっかり
効果が認められた
成分を
使用しているん度恵
安心
薬用ネオテクト
はのびもいいし
べたつかない
肌の引き締め効果も
あるので
至れり尽くせり[/char]
引用 amazon
[char no=”4″ char=”えりこ”]買う前から私がとても
期待していた商品
ワキの汗と
ニオイが
ほとんど
気になら
なくなったので
助かります。[/char]
引用 amazon
[char no=”5″ char=”なつみ”]個人差はあるかもしれませんが
加齢臭
対策にもいいかも
シャワーの後に
薬用ネオテクト
を使うと
一日中効果が期待できます
マスク生活で
鼻から
脂臭が
していたのが
不快感が
ありましたが
嘘のように
なくなりました。[/char]
引用 amazon
[char no=”5″ char=”なつみ”]ウォータープルーフなうえに、汗も
抑えてくれる
出かける前に塗りなおせば
1日中持続します。[/char] 引用 amazon
[char no=”4″ char=”えりこ”] 爽やかな
香りはしませんが、
副産物のような
ニオイもないので安心。[/char] 引用 amazon [char no=”3″ char=”ちさ”] 汗の量も減り
Tシャツの汗シミも減りました
肌に負担がないの
夏でも安心です。[/char]
引用 amazon
薬用ネオテクトの楽天の口コミ
[char no=”4″ char=”えりこ”]効果が長時間持続します
ただ値段が
高いのがマイナス[/char]
引用 楽天
薬用ネオテクトのyahooショッピングの口コミ
[char no=”3″ char=”ちさ”]注文から配送まで
スムーズでした
梱包も良いので
安心でした[/char]
引用 yahooショッピング
薬用ネオテクトのアットコスメの口コミ
[char no=”4″ char=”えりこ”]おしゃれなデオドラントクリーム
仕事で
革靴を
毎日
履いて
いるのですが
帰宅すると
足のにおいが
前日の夜に
これを
塗っておけば
朝に塗りなおし
しなくても臭くないです[/char]
引用 アットコスメ
[char no=”5″ char=”なつみ”]シンプルなパッケージで
とてもかわいい
塗った後は
サラサラ
過去の
デオドラント
クリームは
粉っぽいものが多い
ですが
薬用ネオテクト
は心地よい使用感
1度塗ると
長時間持続します[/char]
引用 アットコスメ
[char no=”4″ char=”えりこ”]ワキ脱毛をしているので
ワキの汗が
増えてきて
悩んでいましネオテクト
を使うと
塗り広げるだけで
翌日の
汗のにおいが
気にならないです
汗の量も減って
Tシャツの汗の
シミが
つくことが
なくなりました[/char]
引用 アットコスメ
ジェルがやわらかく伸びて、ベタつかず使いやすいと感じました。
無香料タイプなので、香りでごまかさないところが気に入っています。
肌に塗ったあとサラッとしていて、衣服につきにくいのが安心です。
ロールオンタイプなので手を汚さずにサッと使えるのが便利でした。
持ち運びやすいサイズ感で、外出先でも使いやすいのが嬉しいです。
薬用なので、毎日安心して取り入れられる感じがします。
汗をかきやすい時期でもサラサラ感が続くのが心地よかったです。
香りでごまかさずにケアできるので、シーンを選ばず使えるところが良いです。
塗った直後にスーッとした清涼感があり、気持ちがリフレッシュできました。
キャップがしっかり閉まるので、ポーチに入れても漏れにくいのが安心でした。
薬用ネオテクトのインスタグラムの評判
この投稿をInstagramで見る
この投稿をInstagramで見る
薬用ネオテクトはPococeでも話題

薬用ネオテクトは
Pococeの
コスメティック部門
BEAUTU
AWARD受賞しました
薬用ネオテクトの体験談!私の本音

[char no=”5″ char=”なつみ”]e家族もみんな
汗っかき
これは
遺伝によるものかな
と半分あきらめてました
でも
夜に近づくにつれて
体臭が..
香水を
つけすぎると
逆効果だし…
どうにかならないかなって
思ってました
友人にこれいいよ
と教えて
もらったのが
薬用ネオテクトでした[/char]
薬用ネオテクトを使って1日目
[char no=”5″ char=”なつみ”]薬用ネオテクトは敏感肌の私
でも刺激なく
使えてます
お風呂上りに
タオルで
しっかり
水を
ふき取った後に
適量使うだけ
翌朝になっても
汗を
かきずらくなり
お肌もさらさら
あの酸っぱい
ニオイが
しないので安心[/char]
薬用ネオテクトを1ヶ月使ってます
[char no=”5″ char=”なつみ”] 薬用ネオテクトを30日間
使ってみました
おかげさまで
慢性的な
汗の問題
から解放
家族みんなで
薬用ネオテクトを
使ってます[/char]
薬用ネオテクトは雑誌でも話題

薬用ネオテクトは
Tarzan
anan
美的
等の雑誌でも話題
またyahooニュース
読売新聞
infoseek楽天 NEWSにも
取り上げられてますよ
薬用ネオテクトの口コミのまとめ

薬用ネオテクト
を使うことで
長年悩んでいた
汗、体臭の
悩みから
すっきり
解放されて
良い評価の人が多いので
安心して
お試しできそうですね
気になる方は
公式サイトを
チェックして
みてくださいね
今なら初回限定2,980円でお試し✨
薬用ネオテクトのメリットとデメリットは
薬用ネオテクトのように
優れたデオドラントケアにも
メリットと
デメリットが存在しますので
知っておきましょう
値段が
市販の制汗剤より
も高い
解約が
電話連絡のみ
ドラッグストアには
ウっ得tない
メリット
安全の日本製
効果が
1日中続く
さらっとした
付け心地で
べとつかない
加齢臭にも
効果がある
持ち運びが楽
汗の量も
減少する
などの
メリットと
デメリットがあります
メリットの方が
多いので
汗のにおいなどで
お悩みの方は
薬用ネオテクトを
試してみましょう[/char]
今なら初回限定2,980円でお試し✨
薬用ネオテクトのメリットとデメリットは
薬用ネオテクトにも
メリットと
デメリットがあるので
紹介します
デメリットは
値段がちょっと高め
解約は電話のみに対応
べとつきを
感じる人もいる
薬用ネオテクトのメリットは
日本製なので
肌に優しい
効果が長時間持続
加齢臭対策に
効果を発揮
汗の量も減って
べたつきずらい
塗るだけなので
とても簡単に使えて便利ですね
【「香水でごまかす」のはもう卒業】
気になる汗・においに本気で向き合うなら今。
30代からのニオイケアに選ばれているネオテクト、数量限定キャンペーン中👇
薬用ネオテクトのまとめ
薬用ネオテクトはべたつきにくく、気になる汗、体臭ケアに役立つアイテムだということがわかりました
薬用ネオテクトの口コミでは
悪いものとしては、汗などをかいている状態では
効果を感じにくいとのこと
これは汗を拭いた状態で使うことで解消できそう
薬用ネオテクトの良い口コミでは汗ジミで困らなくなった
ワキが全然臭わないので安心できるようになった
テクスチャーも軽めで使いやすいとの好印象を持つ方が多いです
薬用ネオテクトの最安値は公式通販です
30%OFFの5580円(税込)でお得なのはもちろん
初めての人でも30日間の返金保証付きで
実質リスクなくお試しが可能なので、ワキガ、脇シミでお悩みの方におすすめです
【周りは気づいてるのに、自分だけ気づけてないかも…】
大人の体臭・汗のにおいは早めのケアが命!
薬用ネオテクトは、殺菌+消臭のW有効成分で悩みを根本ケア👇
もうワキガ、ワキ汗で悩まない!薬用ネオテクトを割引価格で購入する
薬用ネオテクトの販売会社
店舗名
BrandNewStore 公式オンライン
販売業者の名称
株式会社ヴィジョンステイト
運営統括責任者
代表取締役: 渡邉 亙
所在地及び連絡先
〒170-0001
東京都豊島区西巣鴨4-1-7 東京本社ビル1F
デリケート
参考
Highnessリバランスデオの口コミ、評判で本音をチェック!【ワキガ、汗臭に、臭わない肌を育てる柿由来のデオドラント】
デオラデュースの口コミ、評判で本音をチェック!【24時間効果実感!汗、ワキガでお悩みのあなたへ】
クレアリー 消臭剤の口コミ、評判で本音をチェック!【部屋のペットの臭いが気になる方へ】
ウィルクレンズフットクリームで足の汗と匂いを抑えて消臭キープ【天然成分で臭いの元を徹底ケア】
デオ・ソープは薬局、ドラッグストアでも売ってるのか調査!皆さんここで買ってます【体臭やニオイのプロが絶賛】
アイムケア マジックウォッシュの口コミ、評判で本音をチェック!【デリケートゾーンのニオイケアでもう悩まない】
athletia(アスレティア)リフレッシング デオドラントミストの口コミ、評判で本音をチェック!(長時間の殺菌防臭効果を発揮する、みずみずしい薬用デオドラント)
アニセ ワキガ対策クリームの最安値販売店!ドラッグストア、薬局でも売ってるの?【【1日わずか30秒!ワキが臭くなる前の対策!】
バナナリーフ石鹸の最安値販売店!ドラッグストア、薬局でも売ってるの?【気になるワキガをオフ】
薬用イビサデオドラントはドンキでもう売ってるの?最安値の販売店の最新の情報を紹介【デリケートゾーンの気になるニオイをスッキリ】
アノコイデオクレム最安値販売店!皆さんここで買ってます!【初回50%OFF】楽天,amazonでも購入できるのか調査
クリアネオ クリームの口コミでわかるワキガ対策の新常識!悪い口コミで誤解をしない【もうニオイで悩まない】



